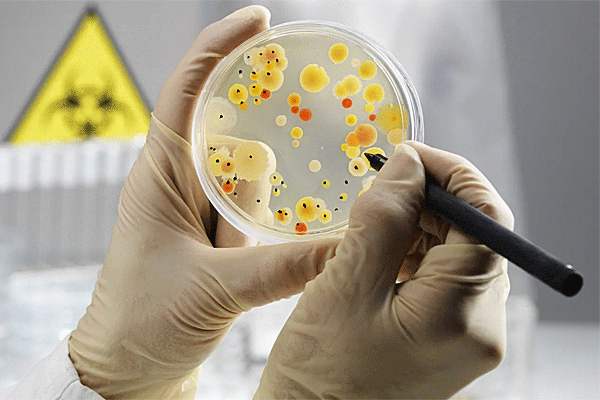

В недавнем редакционном специальном выпуске, опубликованном в журнале «Foods», освещаются текущие проблемы и последние достижения в области обнаружения и контроля зоонозных патогенов (возбудители инфекционных и паразитарных заболеваний, которые передаются человеку от других животных) в продуктах питания и связанных с ними средах.
Примерно у 600 миллионов человек развиваются болезни пищевого происхождения после употребления зараженной пищи, из которых примерно 420 000 умирают. Дети в возрасте до пяти лет составляют почти 30% всех смертельных случаев. Поэтому загрязнение пищевых продуктов считается значительной угрозой для здоровья населения. У людей из стран с низким и средним уровнем дохода развиваются болезни пищевого происхождения из-за неправильного хранения пищевых продуктов, несоблюдения правил гигиены, недостатков инфраструктуры и непоследовательного применения нормативных требований. Растущее появление патогенов пищевого происхождения с множественной лекарственной устойчивостью вызвало необходимость эпиднадзора, просвещения потребителей и оценки противомикробных препаратов.
Патогены, включая Escherichia coli, Salmonella spp., Listeria monocytogenes и Campylobacter spp., вызываютболезни пищевого происхождения с широким спектром симптомов от легких желудочно-кишечных расстройств до более тяжелых, угрожающих жизни состояний.
Вирусные агенты, в том числе норовирус и вирус гепатита А, также представляют собой серьезную угрозу безопасности пищевых продуктов. Некоторые зоонозные патогены оказывают значительное влияние на уязвимые группы населения, включая младенцев, детей ясельного возраста, пожилых людей и людей с ослабленным иммунитетом.
Помимо бактерий, патогенными для человека являются паразиты (Giardia lamblia и Entamoeba histolytica, а также Taenia spp.) и грибы (например, Penicillium, Claviceps, Aspergillus и Fusarium)и могут вызывать заболевания, связанные с пищевыми продуктами.
В редакционной статье обобщены исследования, в которых ученые изучали физиологическую и молекулярную адаптацию пищевых патогенов в условиях стресса окружающей среды.
В редакционной статье также отмечается, что образование биопленки на таких поверхностях, как нержавеющая сталь, стекло и пластик, играет решающую роль в сохранении L. monocytogenes в условиях пищевой промышленности, усложняя усилия по очистке и дезинфекции.
Поскольку стандартные методы обнаружения ISO могут быть неэффективными при определении штаммов aLM, исследователи настоятельно рекомендуют использовать передовые инструменты, такие как MALDI-TOF и геномное секвенирование. Эти методы позволят обнаружить горизонтальный перенос генов на более вирулентный L. популяции моноцитогенов.
Полногеномное секвенирование (WGS) недавно было использовано для выделенияL. Штаммы моноцитогена из готовых к употреблению охлажденных продуктов. Это исследование продемонстрировало потенциал метода WGS для точной идентификации плазмидных элементов, детерминант резистентности, таких как гены brcBC и qacJ, а также мобильных генетических элементов, связанных с персистенцией окружающей среды. Таким образом, WGS может улучшить эпиднадзор и оценку рисков для безопасности пищевых продуктов.
Лонгридное секвенирование с использованием Oxford Nanopore MinION недавно было применено для обнаружения E. coli, продуцирующей токсин Шига (STEC), непосредственно из образцов говяжьего фарша. Этот метод позволяет идентифицировать вирулентные гены в течение нескольких часов в чистых культурах и обогащенных образцах пищевых продуктов. Использование метода длинного секвенирования позволяет не только сократить ручной труд, но и значительно сократить время диагностики при рутинных испытаниях на безопасность пищевых продуктов
Фудомика — это междисциплинарная область, которая сочетает в себе геномику, протеомику, липидомику, метаболомику и биоинформатику для оценки качества продуктов питания и микробиологической безопасности по всей цепочке поставок. В редакционной статье подчеркивается, что геномика также поддерживает программы селекции и аутентификации пищевых продуктов, протеомика и метаболомика помогают оптимизировать профили питания и безопасности продуктов животного происхождения, а липидомика способствует разработке функциональных продуктов питания. Для интеграции этих омиксных наборов данных все чаще требуются передовые вычислительные методы, такие как машинное обучение.
Газовая хроматография-масс-спектрометрия (ГХ-МС) широко используется для обнаружения микробной порчи пищевых продуктов и идентификации токсичных соединений, образующихся в различных пищевых продуктах, включая рыбу, мед, молочные продукты, вино. Однако высокие затраты на внедрение и потребность в специализированной инфраструктуре препятствуют широкому внедрению этих передовых методов раннего выявления патогенов пищевого происхождения.
Исследователи выявили антимикробную активность в природных соединениях, таких как эфирные масла. Saccharomyces cerevisiae и Fusarium solani продемонстрировали высокую чувствительность к эфирным маслам. Аналогично, Staphylococcus aureus, E. Кишечная палочка, плесень в воздухе и дрожжи были эффективно устранены с помощью дыма ладана, натурального санитарного средства. Однако вдыхание мелкодисперсных твердых частиц может иметь неблагоприятные последствия для здоровья. Инкапсулированный сывороточный белок с коричным альдегидом продемонстрировал значительную антимикробную эффективность в отношенииListeria innocua, E. и популяции S. cerevisiae.
Исследования, опубликованные в специальном выпуске, освещают текущие проблемы и новые решения в области борьбы с зоонозными патогенами в пищевом секторе. В нем также был изучен потенциал передовых методов идентификации микробных патогенов, связанных с болезнями пищевого происхождения, и новых противомикробных агентов, полученных из природных источников.
В редакционной статье подчеркивается необходимость стандартизации протоколов, улучшения обнаружения в сложных условиях и интеграции омики с антимикробными стратегиями. Междисциплинарное сотрудничество между технологами пищевой промышленности, микробиологами, биоинформатиками и специалистами в области общественного здравоохранения имеет важное значение для разработки эффективных вмешательств по лечению болезней пищевого происхождения.
Примерно у 600 миллионов человек развиваются болезни пищевого происхождения после употребления зараженной пищи, из которых примерно 420 000 умирают. Дети в возрасте до пяти лет составляют почти 30% всех смертельных случаев. Поэтому загрязнение пищевых продуктов считается значительной угрозой для здоровья населения. У людей из стран с низким и средним уровнем дохода развиваются болезни пищевого происхождения из-за неправильного хранения пищевых продуктов, несоблюдения правил гигиены, недостатков инфраструктуры и непоследовательного применения нормативных требований. Растущее появление патогенов пищевого происхождения с множественной лекарственной устойчивостью вызвало необходимость эпиднадзора, просвещения потребителей и оценки противомикробных препаратов.
Патогены, включая Escherichia coli, Salmonella spp., Listeria monocytogenes и Campylobacter spp., вызываютболезни пищевого происхождения с широким спектром симптомов от легких желудочно-кишечных расстройств до более тяжелых, угрожающих жизни состояний.
Вирусные агенты, в том числе норовирус и вирус гепатита А, также представляют собой серьезную угрозу безопасности пищевых продуктов. Некоторые зоонозные патогены оказывают значительное влияние на уязвимые группы населения, включая младенцев, детей ясельного возраста, пожилых людей и людей с ослабленным иммунитетом.
Помимо бактерий, патогенными для человека являются паразиты (Giardia lamblia и Entamoeba histolytica, а также Taenia spp.) и грибы (например, Penicillium, Claviceps, Aspergillus и Fusarium)и могут вызывать заболевания, связанные с пищевыми продуктами.
В редакционной статье обобщены исследования, в которых ученые изучали физиологическую и молекулярную адаптацию пищевых патогенов в условиях стресса окружающей среды.
В редакционной статье также отмечается, что образование биопленки на таких поверхностях, как нержавеющая сталь, стекло и пластик, играет решающую роль в сохранении L. monocytogenes в условиях пищевой промышленности, усложняя усилия по очистке и дезинфекции.
Поскольку стандартные методы обнаружения ISO могут быть неэффективными при определении штаммов aLM, исследователи настоятельно рекомендуют использовать передовые инструменты, такие как MALDI-TOF и геномное секвенирование. Эти методы позволят обнаружить горизонтальный перенос генов на более вирулентный L. популяции моноцитогенов.
Полногеномное секвенирование (WGS) недавно было использовано для выделенияL. Штаммы моноцитогена из готовых к употреблению охлажденных продуктов. Это исследование продемонстрировало потенциал метода WGS для точной идентификации плазмидных элементов, детерминант резистентности, таких как гены brcBC и qacJ, а также мобильных генетических элементов, связанных с персистенцией окружающей среды. Таким образом, WGS может улучшить эпиднадзор и оценку рисков для безопасности пищевых продуктов.
Лонгридное секвенирование с использованием Oxford Nanopore MinION недавно было применено для обнаружения E. coli, продуцирующей токсин Шига (STEC), непосредственно из образцов говяжьего фарша. Этот метод позволяет идентифицировать вирулентные гены в течение нескольких часов в чистых культурах и обогащенных образцах пищевых продуктов. Использование метода длинного секвенирования позволяет не только сократить ручной труд, но и значительно сократить время диагностики при рутинных испытаниях на безопасность пищевых продуктов
Фудомика — это междисциплинарная область, которая сочетает в себе геномику, протеомику, липидомику, метаболомику и биоинформатику для оценки качества продуктов питания и микробиологической безопасности по всей цепочке поставок. В редакционной статье подчеркивается, что геномика также поддерживает программы селекции и аутентификации пищевых продуктов, протеомика и метаболомика помогают оптимизировать профили питания и безопасности продуктов животного происхождения, а липидомика способствует разработке функциональных продуктов питания. Для интеграции этих омиксных наборов данных все чаще требуются передовые вычислительные методы, такие как машинное обучение.
Газовая хроматография-масс-спектрометрия (ГХ-МС) широко используется для обнаружения микробной порчи пищевых продуктов и идентификации токсичных соединений, образующихся в различных пищевых продуктах, включая рыбу, мед, молочные продукты, вино. Однако высокие затраты на внедрение и потребность в специализированной инфраструктуре препятствуют широкому внедрению этих передовых методов раннего выявления патогенов пищевого происхождения.
Исследователи выявили антимикробную активность в природных соединениях, таких как эфирные масла. Saccharomyces cerevisiae и Fusarium solani продемонстрировали высокую чувствительность к эфирным маслам. Аналогично, Staphylococcus aureus, E. Кишечная палочка, плесень в воздухе и дрожжи были эффективно устранены с помощью дыма ладана, натурального санитарного средства. Однако вдыхание мелкодисперсных твердых частиц может иметь неблагоприятные последствия для здоровья. Инкапсулированный сывороточный белок с коричным альдегидом продемонстрировал значительную антимикробную эффективность в отношенииListeria innocua, E. и популяции S. cerevisiae.
Исследования, опубликованные в специальном выпуске, освещают текущие проблемы и новые решения в области борьбы с зоонозными патогенами в пищевом секторе. В нем также был изучен потенциал передовых методов идентификации микробных патогенов, связанных с болезнями пищевого происхождения, и новых противомикробных агентов, полученных из природных источников.
В редакционной статье подчеркивается необходимость стандартизации протоколов, улучшения обнаружения в сложных условиях и интеграции омики с антимикробными стратегиями. Междисциплинарное сотрудничество между технологами пищевой промышленности, микробиологами, биоинформатиками и специалистами в области общественного здравоохранения имеет важное значение для разработки эффективных вмешательств по лечению болезней пищевого происхождения.